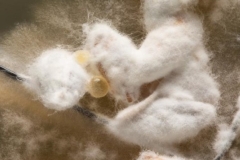

別讓精美郵票成漁貓最后身影
科普時報作者:金 雷
10-25
2023

自然科普:?“滅絕”41年后,陽彩臂金龜再現(xiàn)
科普時報作者:許煥崗
10-25
2023

霜降|為什么霜打的白菜更好吃呢?
科普中國
10-24
2023

無數(shù)從天而降的蜘蛛網(wǎng),覆蓋了美國加州
科普中國
10-23
2023

自然科普:果實:為何花是五顏六色的,而我卻如此單調(diào)?
科普中國作者:中國科普博覽
10-19
2023

洞庭湖迎來今年首批冬候鳥 保護(hù)區(qū)提供全方位“保駕護(hù)航”
新華社作者:周楠
10-17
2023

全國紅葉地圖出爐!你想和誰一起看萬山紅遍?
中國天氣網(wǎng)
10-16
2023
用細(xì)菌和真菌蓋房子,你敢相信嗎?
科普中國作者:Denovo團(tuán)隊
10-13
2023

“張騫嚴(yán)選”,從西域帶回了哪些“好物”?
我i科普微信公眾號
10-12
2023

10年翻山越嶺,終于證明這種水果起源于中國
科普中國作者:大科普
10-12
2023
 會員登錄
會員登錄



















